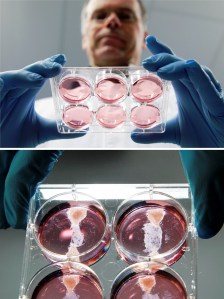
El Dr. Mark Post enseñando la carne fabricada en laboratorio

Científicos del departamento de Fisiología Vascular de la Universidad de Maastricht, liderados por el doctor Mark Post, han anunciado en la revista ‘New Scientist’ que a lo largo de este año podrían crear carne artificial de laboratorio a partir de células madre.
Científicos del departamento de Fisiología Vascular de la Universidad de Maastricht, liderados por el doctor Mark Post, han anunciado en la revista ‘New Scientist’ que a lo largo de este año podrían crear carne artificial de laboratorio a partir de células madre.
Post y su equipo han conseguido fabricar un tejido muscular sin necesidad de sacrificar ningún animal. «No creamos vida sino que usamos vida que ya existe”, ha explicado Post ante lo que podría ser una auténtica revolución.
Sigue leyendo mi artículo en la página web de El Cultural.
Para leer más artículos publicados en El Cultural, clica aquí.



 Escrito por Carlo
Escrito por Carlo 


